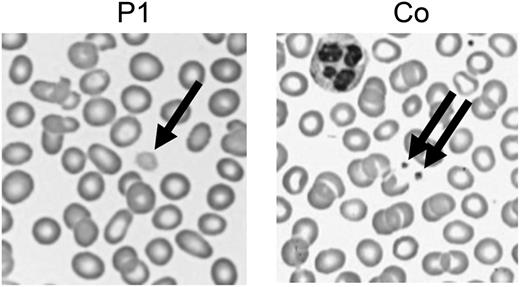
Figure 1. Enlarged platelets. Representative images of a routine peripheral blood smear showing enlarged pale platelets in P1. Co, control.

To the editor:
The combination of splenomegaly and autoimmune cytopenia is frequently associated with primary immunodeficiencies. The most frequent disease is autoimmune lymphoproliferative syndrome (ALPS), caused by autosomal dominant germline or somatic mutations of the FAS gene.1,2 The differential diagnosis can be challenging, but the combination of serum vitamin B12 and soluble FAS ligand (sFASL) has a high predictive value for the presence of FAS mutations and is currently used for screening.
We report 2 siblings of a consanguineous family referred for suspected ALPS with splenomegaly, thrombocytopenia (patient [P]1) or pancytopenia (P2), and multiple autoantibodies (Table 1). Screening of another sister revealed a previously unknown thrombocytopenia. Both parents were healthy. Biomarker screening showed vitamin B12 and sFASL levels significantly above the previously defined cutoff values for all 3 affected siblings but not for the unaffected family members. However, no FAS mutation could be found. In addition, normal interleukin-10 levels, only moderate elevation of double-negative T cells (DNT), and normal FAS-mediated apoptosis argued against a FAS signaling defect. Following informed consent (University of Freiburg ethics protocol number 40/9), we performed homozygosity mapping and whole-exome sequencing, followed by bioinformatic analysis, and detected a homozygous missense variation in PLXNB1 (c.655G>A p.Val219Met), a homozygous missense variation in RRP9 (c.699C>G p.His233Gln), and a homozygous nonsense NBEAL2 mutation (c.5299C>T p.Gln1767*) in the 3 affected siblings. All mutations were confirmed by Sanger sequencing.
Clinical and immunologic characteristics of GPS patients investigated for ALPS
| . | P1 . | P2 . | P3 . | P4 . | P5 . | P6 . |
|---|---|---|---|---|---|---|
| Age at investigation, y | 9 | 3 | 7 | 12 | 15 | 7 |
| Clinical | ||||||
| Cytopenia (nadir platelet count per microliter) | Thrombocytopenia (62 000) | Pancytopenia (47 000) | Thrombocytopenia (50 000) | Thrombocytopenia (55 000) | Thrombocytopenia (43 000) | Thrombocytopenia (35 000) |
| Autoantibodies | Anti-DNA, ANA | Anti-platelet, anti-tPA, ANA, anti-GBM, ANCA | — | — | — | ANA |
| Bleeding history | Mild gum bleeding | Mild gum bleeding | Mild epistaxis | Severe bleeding after 2 surgeries and after mucocutaneous injury | Severe bleeding after 2 surgeries | Mild bleeding |
| Splenomegaly | + | + | — | — | + | + |
| Lymphadenopathy | + (transient) | — | — | — | — | — |
| Other symptoms | — | Frequent infections | — | — | — | Chilblain lupus |
| Age at first symptom | 1 y 10 mo | 1 y 1 mo | >2 y | 1 mo | 4 y | 2 y 6 mo |
| Laboratory | ||||||
| IgG g/L* (normal age range, y) | 23.41 (5.04-14.74) | 10.46 (4.53-9.16) | 16.51 (5.04-14.74) | 10.6 (6.98-15.84) | 13.74 (6.98-15.84) | 18.2 (5.04-14.74) |
| DNT %† (<2.5%) | 2.8 (43/µL) | 1.7 (24/µL) | 2.4 (28/µL) | 1.5 (14/µL) | 2.3 (35/µL) | 5 (57/µL) |
| Vitamin B12,*,‡ mg/dL | 3 856 | >4 000 | >4 000 | 3 758 | 1 843 | >2 000 |
| sFASL,‡ pg/mL (<200) | 759 | 740 | 797 | 549 | 465 | 630 |
| IL-10, pg/mL (<20) | 6.5 | <1 | 4.7 | <1 | <1 | <1 |
| Genetic | ||||||
| NBEAL2 mutation | c.5299C>T p.Gln1767* homozygous | c.5299C>T p.Gln1767* homozygous | c.5299C>T p.Gln1767* homozygous | c.881C>G | c.881C>G | c.4501_4503del p.Leu1501del |
| p.Ser294* and c.958C>T p.Arg320Trp | p.Ser294* and c.958C>T p.Arg320Trp | |||||
| Both homozygous | Both homozygous |
| . | P1 . | P2 . | P3 . | P4 . | P5 . | P6 . |
|---|---|---|---|---|---|---|
| Age at investigation, y | 9 | 3 | 7 | 12 | 15 | 7 |
| Clinical | ||||||
| Cytopenia (nadir platelet count per microliter) | Thrombocytopenia (62 000) | Pancytopenia (47 000) | Thrombocytopenia (50 000) | Thrombocytopenia (55 000) | Thrombocytopenia (43 000) | Thrombocytopenia (35 000) |
| Autoantibodies | Anti-DNA, ANA | Anti-platelet, anti-tPA, ANA, anti-GBM, ANCA | — | — | — | ANA |
| Bleeding history | Mild gum bleeding | Mild gum bleeding | Mild epistaxis | Severe bleeding after 2 surgeries and after mucocutaneous injury | Severe bleeding after 2 surgeries | Mild bleeding |
| Splenomegaly | + | + | — | — | + | + |
| Lymphadenopathy | + (transient) | — | — | — | — | — |
| Other symptoms | — | Frequent infections | — | — | — | Chilblain lupus |
| Age at first symptom | 1 y 10 mo | 1 y 1 mo | >2 y | 1 mo | 4 y | 2 y 6 mo |
| Laboratory | ||||||
| IgG g/L* (normal age range, y) | 23.41 (5.04-14.74) | 10.46 (4.53-9.16) | 16.51 (5.04-14.74) | 10.6 (6.98-15.84) | 13.74 (6.98-15.84) | 18.2 (5.04-14.74) |
| DNT %† (<2.5%) | 2.8 (43/µL) | 1.7 (24/µL) | 2.4 (28/µL) | 1.5 (14/µL) | 2.3 (35/µL) | 5 (57/µL) |
| Vitamin B12,*,‡ mg/dL | 3 856 | >4 000 | >4 000 | 3 758 | 1 843 | >2 000 |
| sFASL,‡ pg/mL (<200) | 759 | 740 | 797 | 549 | 465 | 630 |
| IL-10, pg/mL (<20) | 6.5 | <1 | 4.7 | <1 | <1 | <1 |
| Genetic | ||||||
| NBEAL2 mutation | c.5299C>T p.Gln1767* homozygous | c.5299C>T p.Gln1767* homozygous | c.5299C>T p.Gln1767* homozygous | c.881C>G | c.881C>G | c.4501_4503del p.Leu1501del |
| p.Ser294* and c.958C>T p.Arg320Trp | p.Ser294* and c.958C>T p.Arg320Trp | |||||
| Both homozygous | Both homozygous |
ANA, anti-nuclear antibody; ANCA, anti-neutrophil cytoplasmic antibody; DNT, double-negative T cell; GBM, glomerular basement membrane; IgG, immunoglobulin G; IL, interleukin; tPA, tissue-type plasminogen activator; +, present; —, absent.
Age dependent.
Absolute numbers in parentheses.
Cutoff values associated with high probability of FAS mutation3 : vitamin B12, 1 255 pg/mL; sFASL, 560 pg/mL.
The most plausible disease-causing mutation was the mutation in NBEAL2, coding for a member of the family of BEACH domain–containing proteins involved in membrane dynamics and intracellular vesicle trafficking. Mutations in NBEAL2 (neurobeachin-like 2) cause gray platelet syndrome (GPS), a bleeding disorder with large platelets lacking α-granules.4,5 GPS manifests with mild-to-moderate bleeding, frequently associated with splenomegaly and myelofibrosis. Bleeding diathesis was initially not reported by our patients, but occasional gum bleeding was noted retrospectively. GPS was confirmed by the presence of giant gray platelets (Figure 1) and reduced CD62 (P-selectin) expression in stimulated platelets, indicating defective α-granule secretion.
Enlarged platelets. Representative images of a routine peripheral blood smear showing enlarged pale platelets in P1. Co, control.
Enlarged platelets. Representative images of a routine peripheral blood smear showing enlarged pale platelets in P1. Co, control.
We recruited 3 further GPS patients (P4, P5, and P6; Table 1). One patient with mild bleeding had also been referred for evaluation of ALPS because of splenomegaly and thrombocytopenia in the context of chilblain lupus with detection of antinuclear antibodies. He carried a novel homozygous in-frame deletion in the NBEAL2 gene (c.del4501-4503; p.Leu1501del). The other 2 patients with more severe bleeding and no detectable autoantibodies carried the described homozygous nonsense NBEAL2 mutation (c.881C>G p.Ser294*) and a homozygous missense variation (c.958C>T p.Arg320Trp). All 3 patients had elevated vitamin B12 and sFASL levels (Table 1) and high normal or elevated immunoglobulins.
Raised vitamin B12 levels were previously observed in GPS patients,6 but the pathophysiology is not well understood. Increased vitamin B12 is observed in liver disease, myeloproliferative diseases, myelogeneous and promyelocytic leukemia, and hypereosinophilic syndrome.7 In liver disease, it can be caused by increased release or decreased clearance of cobalamin from the liver; in hematologic diseases by increased production of the carrier protein haptocorrin.7 FAS-mutant ALPS patients also show increased haptocorrin, but the reason for its dysregulated expression is unresolved.8
FASL is expressed by T and natural killer cells. It is upregulated after activation and shed by metalloproteases. In ALPS, massive upregulation of the FASLG gene occurs in double-negative T cells.3,9,10 Raised sFASL levels were also described in diseases associated with excessive T-cell activation, such as hemophagocytic lymphohistiocytosis, chronic infection, and graft-versus-host disease. In the GPS patients described here, T-cell activation markers and sCD25 levels were normal. Thus, raised sFASL levels probably do not result from increased T-cell activation. Autoantibodies have so far not been described in GPS but were found in individuals from 2 different families. B-cell differentiation was normal (data not shown). It is conceivable that autoantibodies are linked to inappropriate release of proinflammatory granule contents normally contained in platelet granules.6 However, second genetic hits in these consanguineous pedigrees are difficult to exclude, and description of further patients is required to confirm this association.
GPS should be considered in patients with splenomegaly, thrombocytopenia, autoantibodies, and elevated vitamin B12 and sFASL levels. The bleeding history can be mild. The intricate way to the diagnosis in the index family may not be unusual in the age of increasing specialization and next-generation sequencing but should not excuse one from looking at platelet morphology on a simple blood smear in any patient with thrombocytopenia including patients with autoantibodies and splenomegaly.
Authorship
Acknowledgments: This work was supported by the German Federal Ministry of Education and Research grants 01EO1303 and 01GM1111B. Exome sequencing and initial bioinformatics analysis was done at the Australian Phenomics Facility, Canberra, Australia. A.E. is supported by a National Health and Medical Research Council Career Development Fellowship.
Contribution: A.R.-E., S.E., and C.S. coordinated the study; S.-Y.Z., A.S., E.M., B.C., and B.N. took care of the patients; I.F. and U.S. carried out diagnostic tests; U.P., M.R.L., R.F., M.C.A., A.E., and K.S. performed genetic analyses including homozygosity mapping and whole-exome sequencing; A.R.-E., A.S., and B.N. collected data; A.S. and B.Z. performed platelet analyses; A.R.-E., U.P., M.R.L., K.S., B.N., R.F., F.R.-L., B.Z., and S.E. analyzed and interpreted the data; A.R.-E. and S.E. wrote the manuscript; and all authors edited the manuscript.
Conflict-of-interest disclosure: The authors declare no competing financial interests.
Correspondence: Stephan Ehl, University Medical Center Freiburg and University of Freiburg, Breisacherstrasse 117 - 2. OG, 79106 Freiburg, Germany; e-mail: stephan.ehl@uniklinik-freiburg.de.